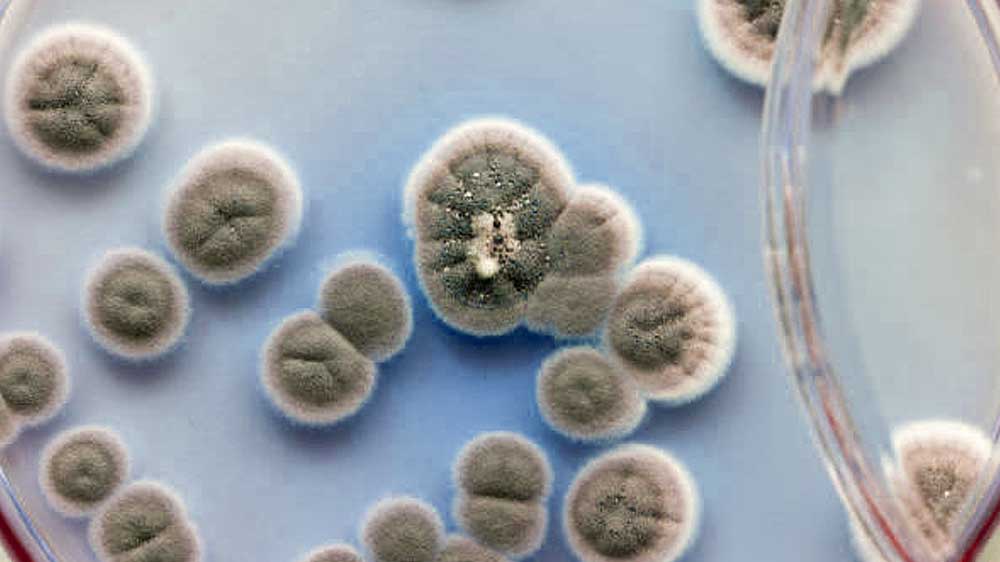

«Η φύση δημιούργησε την πενικιλίνη. Εγώ απλώς τη βρήκα…»
Sir Alexander Fleming
Ο Αλεξάντερ Φλέμινγκ δεν χρειάζεται απολύτως καμία σύσταση: ο άνθρωπος που έσωσε εκατομμύρια άλλους με ένα από τα πρώτα αντιβιοτικά του κόσμου έχει την πενικιλίνη για τις απαραίτητες συστάσεις. Πέρα βέβαια από το ίδιο το φάρμακο που θα γινόταν κοινός τόπος και πάνω του θα χτιζόταν αυτό που ονομάζουμε «σύγχρονη φαρμακολογία», ο Φλέμινγκ μνημονεύεται και για τη συνεισφορά του στην ίδια τη βακτηριολογία, νεοσύστατο κλάδο στα χρόνια του περίφημου γιατρού, που τόσο βοήθησε ο ίδιος να αναπτυχθεί και να περιχαρακώσει την ιδιαίτερη ύπαρξή του.

«Όταν ξύπνησα το πρωί, ασφαλώς και δεν είχα στο μυαλό να φέρω την επανάσταση στην Ιατρική ανακαλύπτοντας το πρώτο αντιβιοτικό στον κόσμο», έγραψε ο Σκωτσέζος φυσικός. «Υποθέτω όμως πως αυτό ακριβώς έκανα…», συμπληρώνει… Στην πραγματικότητα δεν το είχε κάνει μόνος. Ούτε ποτέ ισχυρίστηκε κάτι τέτοιο.
Ο Αλεξάντερ Φλέμινγκ κρατούσε καθημερινό ημερολόγιο. «Είναι ο μοναχικός εργαζόμενος που φέρνει την πρόοδο σε ένα θέμα. Οι λεπτομέρειες μπορεί να εκπονηθούν από μια ομάδα, αλλά η πρωταρχική ιδέα οφείλεται στο εγχείρημα, τη σκέψη και την αντίληψη ενός ατόμου», έγραφε μεταξύ άλλων σκέψεών του. Αλλού πάλι σημειώνει: «Προσπάθησα να επισημάνω ότι στη ζωή μας η τύχη μπορεί να έχει μια εκπληκτική επιρροή και, αν μπορώ να δώσω μια συμβουλή στον νεαρό ερευνητή, αυτή θα ήταν η εξής: να μην αμελεί ποτέ ένα εξαιρετικό συμβάν».
Η χρήση αντιβιοτικών στην υγειονομική περίθαλψη έλκει την καταγωγή της από τις πρώιμες προσπάθειες του κορυφαίου ερευνητή, στον οποίο όλοι μας κάτι χρωστάμε. Ας δούμε λοιπόν τα έργα και τις ημέρες ενός από τα κορυφαία πνεύματα του 20ού αιώνα, που άφησε το στίγμα του ανεξίτηλο στην επιστήμη…

Ο Σερ Αλεξάντερ Φλέμινγκ (Sir Alexander Fleming) γεννήθηκε στο Lochfield, κοντά στο Darvel του Ayrshire της Σκωτίας, στις 6 Αυγούστου 1881. Φοίτησε στο Louden Moor School, στο Darvel School και στην Kilmarnock Academy πριν μετακομίσει στο Λονδίνο, όπου φοίτησε στο Πολυτεχνείο. Πέρασε ακόμα τέσσερα χρόνια σε ναυτιλιακό γραφείο προτού εισαχθεί στην Ιατρική Σχολή του St. Mary’s του Πανεπιστημίου του Λονδίνου. Αποφοίτησε με διάκριση το 1906 και ξεκίνησε έρευνα στο St. Mary’s υπό τον Sir Almroth Wright, πρωτοπόρο στη θεραπεία με εμβόλια. Απέκτησε M.B., B.S. (London), με χρυσό μετάλλιο το 1908 ως ο κορυφαίος φοιτητής ιατρικής της γενιάς του και έγινε λέκτορας στο St. Mary’s μέχρι το 1914.

Στα νεανικά του χρόνια ο Φλέμινγκ ήταν ένθερμο μέλος του εδαφικού στρατού και υπηρέτησε από το 1900 έως το 1914 ως οπλίτης στο Σύνταγμα Σκωτίας του Λονδίνου. Υπηρέτησε καθ’ όλη τη διάρκεια του Α’ Παγκοσμίου Πολέμου ως λοχαγός στο Ιατρικό Σώμα του Στρατού, συμμετείχε σε αποστολές και το 1918 επέστρεψε στο St. Mary’s. Εξελέγη καθηγητής της Σχολής το 1928 και ομότιμος καθηγητής Βακτηριολογίας στο Πανεπιστήμιο του Λονδίνου το 1948. Επίσης εξελέγη μέλος της Βασιλικής Εταιρείας το 1943. Το 1944, έναν χρόνο πριν τη βράβευσή του με το Νόμπελ Ιατρικής, χρίστηκε ιππότης από τον βασιλιά της Μεγάλης Βρετανίας και έκτοτε έφερε τον τίτλο του «σερ».

Πρώιμη καριέρα και ο Α’ Παγκόσμιος Πόλεμος
Ο Φλέμινγκ αποφασίζει να πάρει την ειδικότητα του χειρουργού, από ένα τερτίπι της μοίρας όμως αλλάζει κατεύθυνση: στη σύντομη μαθητεία του στο Τμήμα Εμβολιασμού του νοσοκομείου St. Mary έρχεται σε επαφή με τον νεοσύστατο τομέα της βακτηριολογίας και μαγεύεται. Ο κλάδος τον κερδίζει αμέσως και ρίχνεται με πάθος στην έρευνα. Αναπτύσσει εξαιρετικές ερευνητικές δεξιότητες κάτω από την καθοδήγηση του διαπρεπούς ανοσοβιολόγου Sir Almroth Edward Wright, οι επαναστατικές ιδέες του οποίου για την αποτελεσματικότητα του εμβολιασμού αντιπροσώπευαν μια εντελώς νέα κατεύθυνση στην ιατρική περίθαλψη.
Κατά τη διάρκεια του Α’ Παγκοσμίου, ο Φλέμινγκ υπηρετεί στο Υγειονομικό Σώμα του Βασιλικού Στρατού. Πέρα από το κλινικό του έργο στο πεδίο της μάχης, του δίνεται η δυνατότητα να αφιερωθεί στη βακτηριολογία, μελετώντας μολύνσεις τραυμάτων στο αυτοσχέδιο εργαστήριο που έστησε ο καθηγητής του, Almroth Wright, στο θέατρο επιχειρήσεων της Γαλλίας.

Η επαφή του με τα αντισηπτικά της εποχής θα τον οδηγούσε στο τραγικό συμπέρασμα της κατάφωρης ανεπάρκειάς τους: τα φάρμακα έκαναν περισσότερο κακό παρά καλό στους στρατιώτες! Οι επιζήμιες επιπτώσεις τους στο ανοσοποιητικό σύστημα του ανθρώπου υπερκάλυπταν την ικανότητά τους να αντιπαρατίθενται αποτελεσματικά με τα βακτήρια: ως αποτέλεσμα, περισσότεροι στρατιώτες πέθαιναν από την αντισηπτική θεραπεία παρά από τις μολύνσεις που τα φάρμακα προσπαθούσαν να καταπολεμήσουν. Σε έκθεσή του μάλιστα προς τη στρατιωτική ηγεσία αναφέρει τα ευρήματά του και ισχυρίζεται ότι, για την αποτελεσματικότερη θεραπεία, θα ήταν καλύτερο αν δεν χορηγούνταν αντισηπτικά και κρατούνταν αντιθέτως τα τραύματα στεγνά και καθαρά. Οι προτάσεις του ωστόσο θα αγνοηθούν περνώντας «στα ψιλά» του πολέμου…
Μεταπολεμικές ανακαλύψεις…

Στην αρχή της ιατρικής του ζωής ο Φλέμινγκ άρχισε να ενδιαφέρεται για τη φυσική βακτηριακή δράση του αίματος και για τα αντισηπτικά. Κατάφερε να συνεχίσει τις σπουδές του καθ’ όλη τη διάρκεια της στρατιωτικής του καριέρας και κατά την αποστράτευσή του εστίασε στην εργασία πάνω σε αντιβακτηριακές ουσίες που δεν θα ήταν τοξικές για τους ζωικούς ιστούς. Επιστρέφοντας στο νοσοκομείο St. Mary μετά τα φονικά γεγονότα του πολέμου το 1918, η διοίκηση εμπιστεύεται στον Φλέμινγκ τη θέση του βοηθού διευθυντή του Τμήματος Εμβολιασμών (ο Φλέμινγκ θα γινόταν καθηγητής βακτηριολογίας στο Πανεπιστήμιο του Λονδίνου το 1928 και επίτιμος καθηγητής το 1948).
Τον Νοέμβριο του 1921 ο Φλέμινγκ «αρπάζει» κρύωμα και ανακαλύπτει συμπτωματικά τη «λυσοζύμη», ένα ήπιο αντισηπτικό ένζυμο που κυκλοφορεί στα σωματικά υγρά, όταν ένα φλέγμα από τη μύτη του στάζει μέσα σε καλλιέργεια βακτηρίων! Θεωρώντας ότι κάποια επίδραση πρέπει να έχει το ένζυμο στην αντιμετώπιση των βακτηρίων, αρχίζει να πειραματίζεται με τις… μύξες, αναμιγνύοντάς τες με βακτήρια. Λίγες εβδομάδες μετά, παρατηρεί ότι τα βακτήρια έχουν διαλυθεί…

Το «συμπτωματικό» αυτό γεγονός σηματοδοτεί την πρώτη μεγάλη ανακάλυψή του, που θα είχε κολοσσιαία συνεισφορά τόσο στη βακτηριοθεραπεία όσο και την έρευνα για το ανθρώπινο ανοσοποιητικό σύστημα, παρά το γεγονός ότι πολύ αργότερα θα αποδεικνυόταν ότι η λυσοζύμη δεν είχε καμία επίδραση στα περισσότερα καταστροφικά βακτήρια… Περίπου την ίδια εποχή ο Φλέμινγκ επινόησε μεθόδους ευαισθησίας με δοκιμασίες στο ανθρώπινο αίμα και σε άλλα σωματικά υγρά, τις οποίες στη συνέχεια χρησιμοποίησε για την ανακάλυψη της πενικιλίνης.

Η παρεξηγημένη μούχλα…
Το 1928 ο Αλεξάντερ Φλέμινγκ εργαζόταν πάνω στον ιό της γρίπης. Τον Σεπτέμβριο του ίδιου έτους, έπειτα από έναν μήνα διακοπών με την οικογένειά του, ο Φλέμινγκ επιστρέφει στο εργαστήριό του όπου είχε ξεχάσει μια καλλιέργεια από σταφυλόκοκκο (Staphylococcus aureus). Παρατήρησε τότε ότι η αποικία των βακτηρίων του σταφυλόκοκκου είχε μολυνθεί από μούχλα η οποία είχε δημιουργήσει έναν κύκλο χωρίς βακτήρια γύρω από τον εαυτό της, ενώ ο σταφυλόκοκκος που περιβαλλόταν από μούχλα είχε καταστραφεί! Η έκπληξη του Φλέμινγκ ήταν μεγάλη και η ανακάλυψη αυτή τον ενέπνευσε να πειραματιστεί περαιτέρω, οπότε και διαπίστωσε επανειλημμένα ότι μια καλλιέργεια μούχλας εμπόδιζε την ανάπτυξη των σταφυλόκοκκων ακόμη και όταν αραιωνόταν 800 φορές! Ο Φλέμινγκ ονόμασε τη δραστική ουσία «πενικιλίνη» (Penicillium notatum).

Τριδιάστατο μοντέλο βενζυλπενικιλλίνης

Η χημική ένωση της πενικιλλίνης
Ο Φλέμινγκ συνειδητοποιεί τότε ότι είχε βρει ένα ένζυμο πιο δυνατό από τη λυσοζύμη, ερευνώντας δε περισσότερο ανακαλύπτει ότι δεν επρόκειτο καν για ένζυμο, αλλά για αντιβιοτική ουσία, μία από τις πρώτες μάλιστα που ανακαλύφθηκαν ποτέ! Αντιλαμβάνεται ωστόσο ότι η φαρμακευτική ανάπτυξη της ουσίας δεν μπορούσε να είναι δουλειά ενός μόνον ανθρώπου, όπως όλες οι προηγούμενες προσπάθειές του, και προσλαμβάνει δυο νεαρούς ερευνητές να τον βοηθήσουν στην παραγωγή του αντιβιοτικού. Οι τρεις ερευνητές αποτυγχάνουν όμως ν’ απομονώσουν τον παράγοντα και να τον σταθεροποιήσουν, με τον Φλέμινγκ να ισχυρίζεται ότι παρά την αποτυχία τους η πενικιλίνη διέθετε πράγματι κλινικές δυνατότητες, είτε με τοπική εφαρμογή είτε σε ενέσιμη μορφή και το μόνο που έμενε για να τις φανερώσει ήταν η κατάλληλη ανάπτυξή της.
Οι παραινέσεις του Φλέμινγκ για περαιτέρω έρευνα του αντιβιοτικού παράγοντα θα έκαναν ομάδα επιστημόνων του Πανεπιστημίου της Οξφόρδης, με επικεφαλής τον Howard Florey και τον συνάδελφό του Ernst Chain, να ασχοληθούν με το θέμα, επιτυγχάνοντας ν’ απομονώσουν και να καθαρίσουν την πενικιλίνη. Το αντιβιοτικό θα κυκλοφορούσε τελικά στην αγορά κατά τη διάρκεια των εχθροπραξιών του Β’ Παγκοσμίου Πολέμου, επαναστατικοποιώντας τόσο την ιατρική στο πεδίο της μάχης όσο και γενικότερα τον έλεγχο των λοιμώξεων σε ευρεία κλίμακα.

Το Νόμπελ Ιατρικής
Οι κοινές προσπάθειες των Florey, Chain και Φλέμινγκ για την ανάπτυξη λειτουργικού αντιβιοτικού από την πενικιλίνη θα τους έφερνε ενώπιον της επιτροπής Νόμπελ το 1945, μοιραζόμενοι το Βραβείο Νόμπελ Φυσιολογίας – Ιατρικής εκείνης της χρονιάς. Η σχέση των τριών αντρών επισκιάστηκε ωστόσο από τις σφοδρές αντιπαραθέσεις τους για το ποιος έπρεπε να πιστωθεί με τον έπαινο της ανακάλυψης της πενικιλίνης.

Η απονομή του Νόμπελ Ιατρικής στον Αλ. Φλέμινγκ από τον βασιλιά της Σουηδίας (1945)
Ο Τύπος τόνιζε ιδιαίτερα τον ρόλο του Φλέμινγκ στην όλη υπόθεση, τόσο από την προθυμία του ερευνητή να παραχωρεί συνεχώς συνεντεύξεις όσο και από τις συναρπαστικές λεπτομέρειες πίσω από την ανακάλυψή του: ήταν ο αγαπημένος των εφημερίδων και ο λαϊκός ήρωας που χρειαζόταν ο Τύπος για να πουλά φύλλα. Από την άλλη, επιστημονικοί κύκλοι σημείωναν με νόημα τη συμπτωματικότητα της ανακάλυψης και την αποτυχία της ομάδας του Φλέμινγκ να παρασκευάσει δραστικό αντιβιοτικό…

Ο επιστήμονας που άλλαξε τον κόσμο
Ο Σερ Αλεξάντερ έγραψε πολυάριθμες εργασίες για τη βακτηριολογία, την ανοσολογία και τη χημειοθεραπεία, συμπεριλαμβανομένων των πρωτότυπων περιγραφών της λυσοζύμης και της πενικιλίνης. Έχουν δημοσιευθεί σε ιατρικά και επιστημονικά περιοδικά. Ο Φλέμινγκ, μέλος του Βασιλικού Κολλεγίου Χειρουργών (Αγγλία), 1909, και του Βασιλικού Κολλεγίου Ιατρών (Λονδίνο), 1944, έχει κερδίσει πολλά βραβεία. Διετέλεσε πρόεδρος της Εταιρείας Γενικής Μικροβιολογίας, ήταν μέλος της Ποντιφικής Ακαδημίας Επιστημών και επίτιμο μέλος όλων σχεδόν των ιατρικών και επιστημονικών εταιρειών του κόσμου. Του απονεμήθηκαν επίσης διδακτορικοί τίτλοι, τιμής ένεκεν, σχεδόν τριάντα ευρωπαϊκών και αμερικανικών πανεπιστημίων.

Η ανακάλυψη του Αλεξάντερ Φλέμινγκ έφερε τα πάνω – κάτω στη σύγχρονη ιατρική, αφού άνοιξε τον δρόμο για τη δημιουργία των αντιβιοτικών και την αντιμετώπιση δεκάδων ασθενειών. Καθώς πλησίαζε το έτος 2000, η ανακάλυψη του πρώτου αντιβιοτικού (της πενικιλλίνης) κατατάχθηκε ως η σημαντικότερη ανακάλυψη της χιλιετίας από τρία μεγάλα σουηδικά περιοδικά, όπως το Nyteknik. Είναι αδύνατο να υπολογιστεί πόσες ακριβώς ανθρώπινες ζωές έχουν σωθεί από την ανακάλυψη του Φλέμινγκ, με ορισμένα έγκυρα επιστημονικά περιοδικά να τις εκτιμούν κατά προσέγγιση στα 200 εκατομμύρια! Ελάχιστοι επιστήμονες κατάφεραν να προσφέρουν στην ανθρωπότητα, στη διάρκεια της ζωής τους, τόσα πολλά οφέλη από μία και μόνη ανακάλυψη, όσα ο Αλεξάντερ Φλέμινγκ.

Διαφήμιση του 1940 σε δημόσιο χώρο: «Η πενικιλίνη θεραπεύει τη γονόρροια σε τέσσερις ώρες!»
Προσωπική ζωή και η σχέση του Φλέμινγκ με την Ελλάδα
Το 1915 ο Φλέμινγκ παντρεύτηκε την ιρλανδή νοσοκόμα Sarah Marion McElroy (1881-1949) με την οποία απέκτησε και τον μοναχογιό του Ρόμπερτ (1924-2015), που θ’ ακολουθούσε τα κλινικά βήματα του πατέρα του και θα γινόταν ικανότατος γενικός παθολόγος. Το 1949, ωστόσο, η Sarah πέθανε. Το 1946 ο Φλέμινγκ είχε αναγορευτεί επίτιμος διδάκτορας του Πανεπιστημίου Αθηνών και το 1951 αναγορεύτηκε και επίτιμο μέλος της Ακαδημίας Αθηνών.

Ο Αλεξάντερ και η Αμαλία Φλέμινγκ την ημέρα του γάμου τους
Το 1953 η σχέση του Φλέμινγκ με την Ελλάδα έγινε στενότερη, καθώς νυμφεύτηκε σε δεύτερο γάμο την Ελληνίδα ιατρό Αμαλία Κουτσουρή – Βουρέκα, στενή συνεργάτιδά του στο νοσοκομείο «Σεντ Μέρι» (St. Mary) του Λονδίνου. Ήταν ο δεύτερος γάμος και για την λαίδη Αμαλία, η οποία έγινε ευρύτερη γνωστή ως Αμαλία Φλέμινγκ για την πολιτική δράση της τα χρόνια της χούντας και τα πρώτα χρόνια της μεταπολίτευσης ως μέλος του ΠΑΣΟΚ.
Κατοπινά χρόνια και τιμές
Το 1946, ο Φλέμινγκ διαδέχτηκε τον λαμπρό καθηγητή του Almroth Edward Wright ως επικεφαλής του Τμήματος Εμβολιασμού του νοσοκομείου St. Mary, το οποίο μετονομάστηκε προς τιμήν τους σε «Wright – Fleming Institute». Επιπρόσθετα, ο Φλέμινγκ υπηρέτησε ως πρόεδρος της Society for General Microbiology, τακτικό μέλος της Pontifical Academy of Science και επίτιμο μέλος σε κάθε σχεδόν ιατρικό και επιστημονικό όμιλο και σωματείο του κόσμου.

Εκτός επιστημονικής κοινότητας, ο Φλέμινγκ έγινε πρύτανης του Πανεπιστημίου του Εδιμβούργου (1951-1954), επίτιμος δημότης σε αναρίθμητες πόλεις του κόσμου, ενώ αναγορεύτηκε μέχρι και επίτιμος αρχηγός ινδιανικής φυλής της Αμερικής! Του απονεμήθηκαν επίσης τιμητικοί βαθμοί καθηγητή από 30 και πλέον πανεπιστήμια της Ευρώπης και της Αμερικής.

Το Νοσοκομείο St. Mary του Λονδίνου
Ο Δρ. Αλεξάντερ Φλέμινγκ πέθανε από έμφραγμα του μυοκαρδίου, στις 11 Μαρτίου 1955, σε ηλικία 73 ετών. Η σορός του αποτεφρώθηκε και η τέφρα του φυλάσσεται στον Καθεδρικό Ναό του Αγίου Παύλου του Λονδίνου καθώς ως προς το θρήσκευμα ήταν ρωμαιοκαθολικός.

Προς τιμήν του ονομάστηκε ο αστεροειδής 91006 Φλέμινγκ (Fleming), που ανακαλύφθηκε το 1998. Ομοίως ο μεγάλος κρατήρας Φλέμινγκ (Fleming) στο βόρειο ημισφαίριο της Σελήνης πήρε το όνομά του από τον Αλεξάντερ Φλέμινγκ και την Αμερικανίδα αστρονόμο Williamina P. Fleming (1857-1911) (απόφαση του 1970). Στην Ελλάδα, το Ερευνητικό Κέντρο Βιοϊατρικών Επιστημών «Αλέξανδρος Φλέμινγκ» στη Βάρη επίσης έλκει την ονομασία του από τον κορυφαίο επιστήμονα και πολλές οδοί και πλατείες δήμων της χώρας μας φέρουν τιμητικά το όνομά του.
Πηγές: in.gr, newsbeast.gr, el.wikipedia.org, mediteam.gr